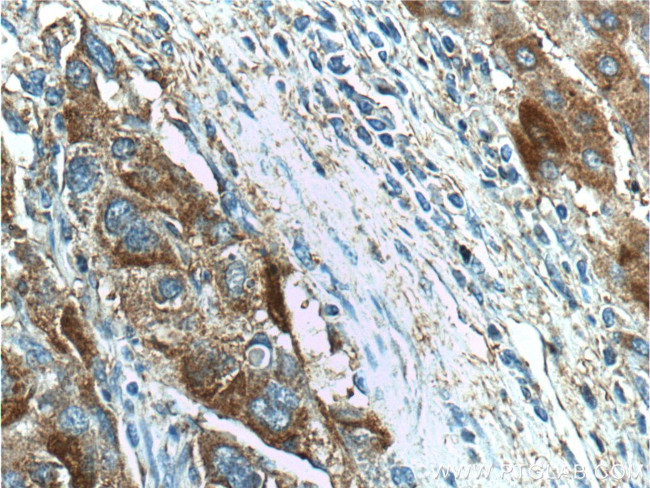
FAM84B Antibody in Immunohistochemistry (Paraffin) (IHC (P))

Search
Proteintech
FAM84B Polyclonal Antibody
{{$productOrderCtrl.translations['antibody.pdp.commerceCard.promotion.promotions']}}
{{$productOrderCtrl.translations['antibody.pdp.commerceCard.promotion.viewpromo']}}
{{$productOrderCtrl.translations['antibody.pdp.commerceCard.promotion.promocode']}}: {{promo.promoCode}} {{promo.promoTitle}} {{promo.promoDescription}}. {{$productOrderCtrl.translations['antibody.pdp.commerceCard.promotion.learnmore']}}
产品信息
18421-1-AP
种属反应
已发表种属
宿主/亚型
分类
类型
抗原
偶联物
形式
浓度
规格
纯化类型
保存液
内含物
保存条件
运输条件
产品详细信息
Immunogen sequence: MGNQVEKLT HLSYKEVPTA DPTGVDRDDG PRIGVSYIFS NDDEDVEPQP PPQGPDGGGL PDGGDGPPPP QPQPYDPRLH EVECSVFYRD ECIYQKSFAP GSAALSTYTP ENLLNKCKPG DLVEFVSQAQ YPHWAVYVGN FQVVHLHRLE VINSFLTDAS QGRRGRVVND LYRYKPLSSS AVVRNALAHV GAKERELSWR NSESFAAWCR YGKREFKIGG ELRIGKQPYR LQIQLSAQRS HTLEFQSLED LIMEKRRNDQ IGRAAVLQEL ATHLHPAEPE EGDSNVARTT PPPGRPPAPS SEEEDGEAVA H (1-310 aa encoded by BC052957)
靶标信息
FAM84B is a protein coding gene.
仅用于科研。不用于诊断过程。未经明确授权不得转售。
生物信息学
蛋白别名: Breast cancer membrane protein 101; breast cancer membrane-associated protein 101; family with sequence similarity 84 member B; LRAT domain-containing 2; neurological/sensory 2; Protein FAM84B; Protein LRATD2; Protein NSE2; unnamed protein product
基因别名: BCMP101; FAM84B; LRATD2; NSE2
UniProt ID: (Human) Q96KN1
Entrez Gene ID: (Human) 157638